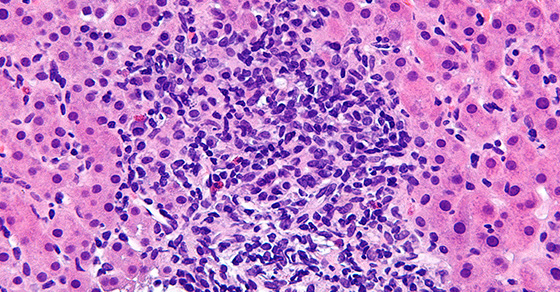
Read the article here.

Mele Kalikimaka a ma Hau’oli Makahiki Hou nani na kanaka! Ho’oli i Ka Ao!
Merry Christmas and a Happy New Year, beautiful people! Joy to the World!
Month: December 2014
Astrology for Christmas Day 2014
Christmas Day is RELATIVELY quiet this year. No heavy duty patterns are in play, or the one or two that arguably remain are breaking up. Even so, let’s identify the issues we can find. The first is the ongoing battle of trust versus betrayal (probably in family settings) with Jupiter (the leader of the gods; the party god and sometimes philanderer) and Juno (Jupiter’s sometimes betrayed wife) near each other in Leo and effectively opposed by Mars (anger, war) and the Moon (our deepest innermost desires and emotions):
[Click Image to Enlarge]
We note that Moon / Mars can represent older children OR another couple (or both) in the drama that unfolds.
We see a secondary set of issues involving Hygeia (health and healthcare) in opposition to Vesta (traditions) and Pluto (death, secrets, and radical change). Christmas squabbles seem to be the routine for many families; this year will not…
View original post 425 more words
Health ~ 9 Toxic Chemicals Found In Furniture

In the article, “Twelve Highly Toxic Chemicals to Banish from Your Home,” Natural News reports on chemicals commonly found around the house that could cause health problems. In particular, several of the chemicals listed there may easily be inside or end up on your furniture where you (as well as your children, friends, and family members) are most likely to ingest them.
Solar-Powered Distiller: Turns Salt Water Into Drinking Water

The world is rapidly reaching global water crisis mode with nearly one billion people lacking access to clean potable water. But a new solar-powered invention can turn seawater into drinking water – and may turn this dire situation around in a hurry.
In the underdeveloped nations of the world, native women travel for miles to local rivers and transport clean water back to their villages in baskets on their heads. The lack of potable water is the cause of typhoid fever and other dreaded maladies stemming from environmental neglect and abject poverty.
How To Know If You’re An Indigo, Crystal Or Rainbow Child

There’s a lot of discussion surrounding the ideas of what a ‘Star Child’ is.
Are you one of them?
If you’re reading this or have an interest in the world’s collective evolution, then you probably are!
These titles or categories of ‘Star People’ hold a different meaning to each person.
To me, this essentially means your purpose in life is to help break down the existing paradigms to really start the shift into our next stages of evolution.
Everyone has bits and pieces of the traits that come with being a Star Person, it’s how you act out your intentions that would make you resonate more with a specific category.
Health ~ Ladies, Are Your Makeup and Body Products Toxic?

Labels on cosmetics and body care products are a tough code to crack. The industry is so shockingly unregulated that it’s usually impossible to trust the claims that manufacturers place on their products. A word such as “natural” can be used by anyone for anything. Even “organic” is misleading. Companies are supposed to use an organic label only if all ingredients are certified-organic, but they can also say it’s “made with organic” if it contains a minimum of 70 percent certified-organic ingredients. Regardless, 30 percent still leaves a lot of room for toxins.
The whole industry has a “innocent-till-proven-guilty” approach to ingredients. Unless a chemical used in beauty products is proven to cause harm to human health, it is classified as GRAS, or “generally recognized as safe.” This classification is upheld by the U.S. FDA and hardly has the best interests of consumers at heart.
The best thing we consumers can do is read ingredient lists carefully in order to avoid chemicals that are known to be harmful, even though they continue to be widely used.
Health ~ Does Your New Year’s Resolution Include Losing Weight?
Before you splurge on some “no-need-to-exercise-to-lose-weight” scheme, like popping diet pills or eating candy lollipops, read up on what the Federal Trade Commission has to say on the matter: The FTC recommends against the use of such diet products marketed with exaggerated claims.
Federal Trade Commision Weighing The Claims In Diet Ads
Claims of Appetite Suppression Using Hoodia Gordonii
CAVEAT EMPTOR … there is no published scientific evidence that indicates hoodia is an appetite suppressant in humans. Meaning? There is NO CLINICAL RESEARCH or scientific studies verifying all the fantastic claims. If there were verifiable results, why isn’t the formula patented and CLINICALLY PROVEN to be effective? Because hoodia gordonii (popularly promoted as “diet lollipops”) is sold as a dietary supplement, hoodia proponants escape the level of scrutiny the FDA gives prescription drugs and medications sold over the counter!!
These are important things to consider when spending your hard-earned cash on items that are more like deceptive hype, rather than true medicine. Don’t be fooled by the loosely tossed around term “organic”!!!! Be smarter in 2015, folks.
WebMD ~ Hoodia: Lots of Hoopla, Little Science
That notion of diet candy has been the scam since the ’60s, it’s not a revolutionary approach, nor has it ever been scientifically-researched … remember the Ayds diet toffees our mothers used? Diet candies didn’t work then, and they don’t work now. Behavior modification and adopting more sensible eating habits that cut out junk foods (high fructose corn syrup candy is junk, hello?) are the keys to achieving true weight loss.

Health ~ Cannabis Shrinks Brain Tumors Associated With Highly Aggressive Forms of Cancer

A tandem approach to shrinking brain tumors with two of marijuana’s key ingredients — tetrahydrocannabinol and cannabidiol — has proven successful, according to the result of a newly published study.
Cannabis has enjoyed a meteoric rise in the United States as of late. Recreational use was recently approved in Oregon and Washington, D.C., and many more states are currently onboard for its letting people use it as medicine. This boom coincides with greater research into the ways in which cannabis acts on the brain’s cannabinoid receptors, alleviating pain, restoring appetite, and, now, shrinking tumors.
Hau’oli aloha Po’akolu
Health ~ 4 Common Mascara Ingredients That Can Harm Your Health

Ladies will attest to the fact that having thick, long eyelashes is a beauty must in order to achieve a classic and dramatic look. Mascara, one of the 10 must-have items in a woman’s makeup bag, is an easy way to go from plain Jane to a pin up queen in seconds, says Discovery Health. The eyelash enhancing product has seen a boost in sales in the global market with an estimated figure of around one billion units sold annually, reports Premiumbeautynews.com. In the United States, mascara is ranked as the second most used every day cosmetic by 65 percent of women, while lip gloss and lip stick is ranked as the most used every day product by 75 percent of women. The rise in daily makeup usage by American women is attributed to the fact that nearly half of the women surveyed by The Beauty Company believe wearing makeup gives them an advantage at work and makes them feel more in control. While a mascara wand can provide self-confidence by throughg longer and voluminous lashes, the toxic ingredients found in this beauty product can be absorbed into the body and potentially have a negative impact on your health.
Daily Affirmation
Just for Today
Think about and create a balance between Life and Work …
Often times we can feel overwhelmed by what we see as competing values: how can I be a good family member, a loving spouse, a supportive friend, pursue my hobbies and interests and maintain my career? For many of us, integrating all of these elements into a fulfilling and rewarding personal life and career is difficult.
Here’s an idea: Think about a person who you feel brings together all the parts of their life in a way that makes them successful. Identify three traits they have or values they embody that makes them successful and figure out how you can better integrate these characteristics into your own life.
Not only is it possible to create a greater sense of harmony among the different parts of your life while achieving greatness, it is necessary.
Hau’oli Aloha Po’alua
Saturn Enters Sagittarius (December 2014)
Here is the chart for the entry of Saturn into Sagittarius:
[Click to Image to Enlarge]
We note that Saturn is in the same “Septile T” configuration that we mentioned previously:
[Click Image to Enlarge]
Given the involvement of Chiron and Juno (healing and trust issues), and that Saturn has now entered Sagittarius (courts and the legal system, among others), we can expect to see some important events in the legal system. This is potentiated by a Thor’s Hammer that is also in play:
[Click Image to Enlarge]
Juno (trust and betrayal), the Sun, and Astraea (law and the legal system) compose the Thor’s Hammer and emphasize, again, the legal system.
Here is the U.S. Map:
[Click to Image to Enlarge]
We note line crossings in (1) Northern Alabama (NASA has an important center there) and (2) San Francisco. Here is the chart relocated to San Francisco:
[Click Image to…
View original post 69 more words
Health ~ Top 9 Herbs To Cleanse The Lungs

Every day we inhale things that cause damage to our lungs. Whether it’s from the toxins we use to clean the house and car, the fumes at the gas station, or the air pollution that’s in the air, our lungs sure take a beating. Also, if you are one of the many people who already suffer from a respiratory condition such as COPD or asthma, this only complicates matters further.
Asthma affects millions of Americans and COPD causes thousands of deaths every year. You can help manage respiratory conditions naturally by consuming herbs that Mother Nature provides us with to support and cleanse the lungs and will help you to breathe easier.
Hau’oli Aloha Po’akahi

Aloha kakahika e ma Hau’oli Aloha Po’akahi oukou. Mahalo Ke Akua no keia la.
Good morning and Happy Aloha Monday, everyone. Thank God for this day.
‘Ike ‘ia no ka loea i ke kuahu … An expert is recognized by the altar he builds.
— ‘Olelo No’eau Hawai’i (Hawaiian Proverb)
What one does and how well one does it is what demonstrates knowledge, skill and expertise.
Just for Today
What does life mean to you? Bring a taste of life to a hospice-bound and/or elderly friend or acquaintance this week by accompanying them in some way for a short time. Counteract their boredom, loneliness and helplessness by infusing in life to bring back a level of quality to Life. Cats, dogs, birds and green plants in every room, and visiting children after school, triggers unexpected transformations.
“Where there’s life, there’s hope.” ~ Marcus Tullius Cicero
Daily Words of the Buddha ~ December 21, 2014
I Ching ~ Week of December 22, 2014

Above: Dui — Responsive, free, penetration
Below: Qian/Gan — Enduring Spirit power
The Wisdom:
Breakthrough;
No compromise.
As you part from the past
You are in a time of creative transformation.
Your struggle against negativity is ending, and you and your projects are now favored. Resist the temptation to take the path of retribution to what or who has been getting in the way of completion or joy, all the while remembering that guides and teachers often come in strange disguises, shapes, and forms. Though it may feel satisfying in the short term to strike out with words or actions against who or what has been holding back your progress, know that what you do now and how you behave is setting the pattern for your personal and our collective future. If you were to respond with spite or negativity, this would reinforce an old pattern pattern that would once again take you to the very same of darkness that has been the obstacle that has been rooted in doubt and frustration.
The decision to part from the past must be resolute, with no doubts and no compromise. You must shift frequencies. If there are a few bad cells left behind after a cancer has been excised, the cancer will come back and secretly grow with the vengeance of a defeated enemy that has found strength in retreat and kill you, your spirit and obliterate your mission.
This is the time to speak from your heart to your tribe and loved ones, letting them know in no uncertain terms that you have decided that you will no longer allow any obstacles to block the way toward the greater good—for you, for the ones you care for and love, and for all of us. Take the role of service to this ideal as a Samurai warrior defending the enlightened master; in this case the master is you. State your intention and then calmly and dispassionately act on it. Write your intention on a piece of paper and keep it in your pocket, take it out read it often during your day. State it upon arising, state it as you prepare to sleep. By speaking out, you will be garnering strength from the universe and from Spirit. By speaking your truth, the laws of attraction say you will become the attractor. Spirit will be pleased at your resoluteness in this situation, and this signaling will bring immense, clarifying energy to you.
Speak and demonstrate in your relationships that you have decided to overcome all obstacles that do not allow love and harmony to flourish. With the intention to love with an open heart, you will find great strength; this will allow you to love and be loved without the restrictions of ego, judgment or jealousy. This will also eviscerate any notions that you are not good enough or deserving of the love you envision and deserve. With calmness and clear direction, make your plans and execute them. That is what is called for now by the arrival of this hexagram.
The planet is in a mode of great change; more energy for transmutation is available than ever before. If you were to act from ego and attempt to use this energy blast to assume control or bring injustice or harm to another, this harm would come back to you to a mathematical power that will be destructive. It will poison the well and wreak harm to yourself for sure, but you would also do harm to the delicate flowering of a new age that is opening before us. We are moving toward a golden age of the highest and brightest potential humans have ever known. Our individual thoughts and actions are now magnified and reverberate throughout the global cosmic matrix that is being activated at this time. Listen to and read the astrologers at this time and you will see the planetary alignments are telling us this, now.
You can dance in the dark no longer, nor can you form secret pacts with yourself or others to promote or be of service to greed or personal gain. If you do make a decision or choice in this direction, it will backfire on you, and all that you have manifested thus far will be tainted and toxic; you will be made powerless. At this time, negative actions will reverberate through a lifetime—this lifetime and future ones; that is how powerful these times and these energies are. So be cautious and stay awake!
With this breakthrough, you now have renewed strength and a window of opportunity to set things straight, whether in business, love, or on your personal path of spiritual evolution. The way you handle this arriving success and the abundance it brings will set the tone for the future. This is a time to express your resolve and manifest your greatest strength, which is your compassion, kindness, and generosity.
Stand firm now and act decisively; you have the strength to make battles short and focused. Keep your emotions out of it. Know that any retribution will weaken you and rob you of your ability to enjoy and sustain your success. Stay out of others’ business and don’t fall to the level of gossip or disrespect in your triumphs. Do not disparage your opponents in their defeat. Forgive them; they know not what they do. And fully and most importantly, forgive yourself for any part you may have played in the negative actions of the past. In this way you truly leave the past behind.
Be dignified and compassionate as you do the work to leave old, negative habits and patterns behind. It is with these actions that you will rise to new heights of self-love and self-respect. From that pinnacle you will find and attract love and abundance in ways you have desired and have previously held only in your imagination. This is a time of creative transformation, and with intention from your loving heart you will manifest in calmness and with grace. In this way your transformation will, in itself, be without effort.
Take note that Guai comes with a caveat: even in times of enlightenment, darkness, in the form of the ego’s desire for control hides just around the corner to tempt you; don’t go for it! As you move forward, do not compromise your beliefs. This would disempower you on your journey toward the resurrection and building of your dreams and plans that previously may have hit a wall of obstruction. The benefit now is to intone to the Spirit Helpers what your dreams are….if you don’t have a dream, how will you have a dream come true
Your intuitive forces are now in their most available light and can be accessed and trusted, as it is you and only you that can bring about the global change we are all envisioning. Speak openly of a new paradigm. Take these coming days to celebrate life and the shift of the ages that is happening now. Do consider being of service now—find joy in serving others with whatever you have at hand. In this way you can lift your tribe up into the light you are seeing and feeling now. By empowering others, you are, with pure intention, empowering yourself.
Be of love these days. Smile to others at work, in your community, in class, on the street, as you drive past them on life’s highway, the highway of love and of a life well lived.
Be love, teach peach,
Make Christmas you personal resurrection and
make love, not war !
Peace and blessings,
BobbyK
Hau’oli Aloha Lapule
Shamanic Journey
Happy 15th Anniversary, Halau!
DECEMBER 21, 2014 ~ Happy 15th Anniversary to our Halau … it’s my heartfelt Honor to share my family’s knowledge and ancestry with all of you. May we continue our Journey Together for many more years to come … Aloha pumehana a me Mahalo nui loa oukou!
Lanakilaonakupuna, Kumu ‘Ekahi
Halau ‘Aha Hui Lanakila
Founded 1999 (this time around)
Seeds for Meditation
Morning Meditation (1 hour)
(works best with earphones on!)
Hauʻoli aloha Poʻaono
Seeds for Meditation
A Tour Around Your Toxic Household!
Toxic chemicals in the home can be eliminated simply by making thoughtful choices. In the supermarket after educating oneself about where the hazards are in common consumer products. How can you determine what toxics you have in your home? Take this “toxic tour
In the Kitchen
All -purpose cleaner, ammonia-based cleaner, bleach, brass or other metal polishes, dishwater detergent, disinfectant, drain cleaner, floor wax or polish, glass cleaner, dishwashing detergent, oven cleaner, and scouring powder contain dangerous chemicals. Some examples are:
Sodium hypochlorite (in chlorine bleach): if mixed with ammonia, releases toxic chloramine gas. Short-term exposure may cause mild asthmatic symptoms or more serious respiratory problems;
Petroleum distillates (in metal polishes): short-term exposure can cause temporary eye clouding; longer exposure can damage the nervous system, skin, kidneys, and eyes.
Ammonia (in glass cleaner): eye irritant, can cause headaches and lung irritation.
Phenol and cresol (in disinfectants): corrosive; can cause diarrhea, fainting, dizziness, and kidney and liver damage.
Nitrobenzene (in furniture and floor polishes): can cause skin discoloration, shallow breathing, vomiting, and death: associated with cancer and birth defects;
Formaldehyde (a preservative, in may products): suspected human carcinogen strong irritant to eyes, throat, skin, and lungs.
In the Utility Closet
A number of products are likely to contain toxic ingredients: carpet cleaner, room deodorizer, laundry softener, laundry detergent, anti-cling sheets, mold and mildew cleaner, mothballs, and spot remover all usually contain irritant or toxic substances. Examples:
Perchloroethylene or 1-1 trichloroethane solvents (in spot removers and carpet cleaners): can cause liver and kidney damage if ingested, perchloroethylene is an animal carcinogen and suspected human carcinogen;
Naphthalene or paradichlorobenzene (in mothballs): naphthalene is a suspected human carcinogen that may damage eyes, blood, liver, kidneys, skin, and the central nervous system; paradichlorobenzene can harm the central nervous system, liver, and kidneys.
Hydrochloric acid or sodium acid sulfate in toilet bowl cleaner; either can burn the skin or cause vomiting diarrhea and stomach burns if swallowed; also can cause blindness, if inadvertently splashed in the eyes.
Residues from fabric softeners, as well as the fragrances commonly used in them, can be irritating to susceptible people.
Possible ingredients of spray starch (aside from the starch) include formaldehyde, phenol, and pentachlorophenol. In addition, any aerosolized particle, including cornstarch, may irritate the lungs.
In the Living Room and Bedroom
Even the furnishings of the typical American home can be harmful. Fabrics that are labeled “wrinkle-resistant” are usually treated with a formaldehyde resin. These include no iron sheets and bedding, curtains, sleep wear, any woven fabric, but especially polyester/cotton blends, marketed as “permanent press” or “easy care.” More modern furniture is made of pressed wood products emits formaldehyde and other chemicals. Carpeting is usually made of synthetic fibers that have been treated with pesticides and fungicide. Many office carpets emit a chemical called 4 phenylcyclohexene, an inadvertent additive to the latex backing used in more commercial and home carpets, which is thought to be one of the chemicals responsible for “sick” office buildings.
In the Bath
Numerous cosmetics and personal hygiene products contain hazardous substances. Examples: cresol, formaldehyde, glycols, nitrates/nitrosamines and sulfur compounds in shampoos; butane propellants in hair spray (replacing carcinogenic methylene chloride), as well as formaldehyde resins; aerosol propellants, ammonia, formaldehyde, triclosan , aluminum chlorhydrate in antiperspirants and deodorants’ glycols, phenol, fragrance, and colors in lotions, creams, and moisturizers.
In the Studio or Hobby Room
Although legislation controlling may of the dangerous ingredients in hobby materials has recently been passed, exposure to certain art materials remains a health risk. Dangerous chemicals and metals include: cadmium in silver solders, pigments, ceramic glazes and fluxes; chromium in paint pigments and ceramic colors; manganese dioxide in ceramic colors and some brown oil and acrylic paint pigments; cobalt in some blue oil and acrylic paint pigments; formaldehyde as a preservation in many acrylic paints and photographic products; aromatic hydrocarbons in paint and varnish removers, aerosol sprays, permanent markers, etc.; chlorinated hydrocarbons (solvents) in ink, varnish, and paint removers, rubber cement, aerosol sprays; petroleum distillated (solvents) in paint and rubber cement thinners, spray adhesive, silk screen inks; glycol ethers and acetates in photography products, lacquer thinners, paints, and aerosol sprays.
In the Garage
A number of dangerous substances are frequently present, including paint, paint thinner, benzene, kerosene, mineral spirits, turpentine, lubricating/motor oils, and gasoline. Hazards among them include these chemicals: chlorinated aliphatic and aromatic hydrocarbons in paint thinner can cause liver and kidney damage; petroleum hydrocarbons, an ingredient of gasoline, motor oils, and benzene, are associated with skin and lung cancer; mineral spirits in oil based paint are a skin, eyes, nose throat, and lung irritant. High air concentrations can cause nervous system damage, unconsciousness and death; ketones in paint thinner may cause respiratory ailments; vary according to specific form of the chemical; ketones and toluene in wood putty; toluene in highly toxic, may cause skin, kidney, liver, central nervous system damage; may damage reproductive system.
In the Garden Shed
Pesticides, one of the most important single hazards in the home. Around 1,400 pesticides, herbicides, and fungicides are ingredients in consumers products. Combined with other toxic substances such as solvents, pesticides are present in more than 34,000 different product formulations.
On the Patio
Charcoal lighter fluid contains petroleum distillates. Besides being flammable and imparting a chemical taste to food, some petroleum distillates contain benzene, a known human carcinogen.
Safe Substitutes for Household Toxics
Until World War II and the zenith of the Chemical Age that followed war-related research, householders use a limited number of simple substances to keep most objects in the house clean, order-free, and pest-free. Soap, vinegar, baking soda, washing soda, ammonia, borax, alcohol, cornstarch, and certain food ingredients were used to lift out spots and stains, deodorize, polish wood or metal, disinfect, scrub, repel pests, clean pets, wash and starch clothes, and to perform countless other household tasks. Simple cosmetic preparations kept hair and skin supplied with the aid of ingredients such as: eggs, oil , clay, vinegar, and herbs.
The garden was fertilized and pests were kept down with naturally occurring substances. Weeds were weeded by hand even though some natural pesticides, like nicotine and rotenone, were indeed toxic to humans, they were not persistent in the environment. They degrade soon after application. Pyrethrum, a pesticide derived from a variety of chrysanthemum, which is nontoxic to mammals, controlled a wide spectrum of pests. Although it is till widely used, it is usually mixed with other chemicals to increase its potency.
Buildings of the past were made with wood, brick, stone, glass, plaster, and cement. Furniture was made of solid wood, oiled to keep it polished. Rugs or carpets were made of wool or cotton. Insulation was built in by making walls thick, and roofing was constructed from wood shingles or tiles of clay or stone. Walls were plastered. Windows were made to be opened, so at least in good weather there was plenty of natural ventilation.
But, toxic materials also were present in homes of the past. Not knowing enough about their hazards, housewives used such chemicals as: arsenic, lead , and mercury to perform certain household chores. Interior and exterior paints were often made with lead; many American children are still living with the legacy of lead poisoning caused by eating chips of leaded paint. Asbestos, called a miracle mineral, when its fire resistant properties were discovered, is now known to be a cancer causer that contaminates hundreds of thousands of residences, schools, and other buildings in this country.
We do not need to return to the ways of the past to avoid exposure to house toxics, but we can take some lessons from the past for a better future. How can we do this?
But Safe Substitutes. For example, search for a soap based garden insecticide (at least one national brand is available) instead of chemically based ones. Appendix 1 for sources of safe substitutes.
When in Doubt, Leave it Out. In cases where there is no effective safe substitute for a toxic product, reevaluate how important the goal really is. Must you absolutely get rid of all insects in your garden? or can you live with some chewed up leaves? If the goal is absolutely imperative, such as ensuring that termites do not invade your house, it is important to educate yourself thoroughly. You may have more healthful alternatives than your local pest company tells you.
Safe Substitutes in the Kitchen and Bath
One shelf of simple and relatively safe ingredients can be used to perform most home cleaning chores. All that’s needed is a knowledge of how they work and how different ingredients should be combined to get the cleaning power needed for a specific job.
Baking Soda is sodium bicarbonate. It has a number of useful properties. It can neutralize acid, scrub shiny materials without scratching, deodorize, and extinguish grease fires. It can be used as a deodorizer in the refrigerator, on smelly carpet, on upholstery and on vinyl. It can help deodorize drains. It can clean and polish aluminum, chrome, jewelry, plastic, porcelain, silver, stainless steel, and tin. It also softens fabrics and removes certain stains. Baking soda can soften hard water and makes a relaxing bath time soak; it can be used as an underarm and as a toothpaste, too.
Borax is a naturally occurring mineral, soluble in water. It can deodorize, inhibit the growth of mildew and mold, boost the cleaning power of soap or detergent, remove stains, and can be use with attractants such as sugar to kill cockroaches.
Cornstarch, derived from corn, can be used to clean windows, polish furniture, shampoo for carpets and rugs, and starch clothes.
Isopropyl Alcohol is an excellent disinfectant.
Lemon Juice, which contains citric acid, is a deodorant and can be used to clean glass and remove stains from aluminum, clothes, and porcelain. It is a mild lightener or bleach if used with sunlight.
Mineral Oil, derived from seeds, is an ingredient in several furniture polish and floor wax recipes.
Soap (NOT detergent) is made in several ways. Castle soap can be used as a shampoo or as a body soap. Olive oil based soap is gentlest to the skin. An all purpose liquid soap can be made by simple dissolving the old ends of bar soap (or grated slivers of bar soap) in warm water.
Steel Wool is an abrasive strong enough to remove rust and stubborn food residues and to scour barbeque grills.
TSP is trisodium phosphate, a mixture of soda ash and phosphoric acid. TSP is toxic if swallowed, but it can be used on many jobs, such as cleaning drains or removing old paint, that would normally require much more caustic and poisonous chemicals, and it does not create any fumes.
Vinegar is made from soured applied juice, grain, or wine. It contains about 5 percent acetic acid, which makes it a mild acid. Vinegar can dissolve mineral deposits, grease, remove traces of soap, remove mildew or wax buildup, polish some metals, and deodorize. Vinegar can clean brick or stone, and is an ingredient in some natural carpet cleaning recipes. Use vinegar is normally used in a solution with water, but it can be used straight.
Washing Soda or Salt Soda is a sodium carbonate decahydrate, a mineral. It can cut stubborn grease on grills, broiler pans, and ovens. It can be used with soda instead of laundry detergent, and it softens hard water. These items are available from drug and chemical supply stores.
For common household tasks, try these nontoxic strategies using the above ingredients:
Freshen Air by opening windows and doors for a short period; distribute partially filled dishes of vinegar around the kitchen to combat unpleasant cooking odors; boil cinnamon and cloves in a pan of water to scent the air; sprinkle 1/2 cup borax in the bottom of garbage pails or diaper pails to inhibit mold and bacteria growth that can cause odors; rub vinegar on hands before and after slicing onions to remove the smell; use bowls of potpourri to give inside air a pleasant scent.
All purpose cleaner can be made from a vinegar and salt mixture or from 4 tablespoons baking soda dissolved in 1 quart warm water.
Disinfectant means anything that will reduce the number of harmful bacteria on surface. Practically no surface treatment will completely eliminate bacteria. Try regular cleaning with soap and hot water,or mix 1/2 cup borax into 1 gallon of hot water to disinfect and deodorize. Isopropyl alcohol is an excellent disinfectant, but use gloves and keep it away from children.
Drain cleaner. Try a plunger first, though not after using any commercial drain opener. To open clogs, pour 1/2 cup baking soda down drain, add 1/2 cup white vinegar, and cover the drain. The resulting chemical reaction can break fatty acids down into the soap and glycerine, allowing the clog to wash down the drain. Again, do not use this method after trying a commercial drain opener the vinegar can react with the drain opener to create dangerous fumes.
Floor cleaner and polish can be as simple as a few drops of vinegar in the cleaner water to remove soap traces. For vinyl or linoleum, add a capful of baby oil to the water to preserve and polish. For wood floors, apply a thin coat of 1:1 oil and vinegar and rub in well. For painted wooden floors, mix 1 teaspoon washing soda into 1 gallon hot water. For brick and stone tiles, use 1 cup white vinegar in 1 gallon water and rinse with clear water.
Metal cleaners and polishes are different for each metal– just as in commercial cleaners. Clean aluminum with a solution of cream of tartar and water. Brass may be polished with a soft cloth dipped in lemon-and baking soda solution, or vinegar- and solution. Polish chrome with baby oil. vinegar, or aluminum foil shiny slide out. Clean tarnished copper by boiling the article in a pot of water with 1 tablespoon salt and 1 cup white vinegar, or try differing mixtures of salt, vinegar, baking soda, lemon juice, and cream of tartar. Clean gold with toothpaste, pewter with a paste of salt, vinegar, and flour. Silver can be polished by boiling it in a pan lined with aluminum foil and filled with water to which a teaspoon each of baking soda and salt have been added. Stainless steel can be cleaned with undiluted white vinegar.
Oven cleaner. Sprinkle baking soda on moist surface and scrub with steel wool, or use Arm & Hammer Oven cleaner, declared nontoxic by Consumers Union.
Scouring power can be made from baking soda or dry table salt. Or try Bon-Ami Cleaning Power or Bon-Ami Polishing cleaner.
Toilet bowl cleaner can be made from straight bleach (do NOT mix with any other substance except water), baking soda and vinegar, or borax and lemon juice.
Tub and tile cleaner can be as easy as rubbing in baking soda with a damp sponge and rinsing, or wiping with vinegar first and following with baking soda as a souring powder.
Window and glass cleaner is easy with these tips: to avoid streaks, don’t wash windows when the sun is shining. Use a vinegar-and -water solution, cornstarch-vinegar-and-water solution, or lemon juice and water. Wipe with newspaper unless you are sensitive to the inks in newsprint.
Safe Substitutes for Laundry Products
Detergent is specially adapted to clean synthetic fabrics, and it has the added advantage of not leaving soil residues even in hard water. However, detergents are generally derived from petrochemicals, and people are sensitive to these compounds may find it hard to tolerate detergents or the fragrances they are scented with. In addition, most detergents contain phosphates, which build up in streams, lakes and upset the natural balance in waterways, causing blooms of algae which deplete the dissolved oxygen fish need to live. Some detergent may even contain naphthalene or phenol, both hazardous substances.
An effective alternative to using detergents is to return to soap. Soap is an effective cleaner for natural fabrics, leaving such items as diapers softer than detergent can. For cotton and linen, use soap to soften water. A cup of vinegar added to the wash can help keep colors bright (but Do NOT use vinegar if you are using bleach — the resulting fumes are hazardous). One half to three quarters of a cup of baking soda will leave clothes soft and fresh smelling. Silks and wools may be hand washed with mild soap or a protein shampoo, down or feathers with mild soap or baking soda.
For synthetic fabrics or blends (including most no-iron fabrics), there are biodegradable detergents on the market that do not contain phosphates, fragrances, or harsh chemicals. They are often imported from Europe and are available at health food stores or by mail order.
Safe Substitutes for Personal Hygiene and Cosmetic Products
We use cosmetics and hygiene products for a fairly narrow range of reasons: to keep skin moist and supple; to clean hair without stripping it of natural oils; to eliminate unpleasant body or mouth orders; to prevent skin oiliness and clogged skin pores; and simply for the pleasure of relaxing and pampering ourselves with body care or facial care treatments. The following ingredients can help achieve these purpose without the use of toxic additives, synthetic fragrances, or artificial colorings: Moisturizers and conditioners egg yolk, milk, yogurt safflower oil (for light moisturizing), olive oil (for dry skin or hair), water, oatmeal, jojoba oil.
Astringents/after shaves: witch hazel, diluted isopropyl alcohol.
Deodorants: baking soda, white clay, deodorant crystals.
Toothpastes: baking soda, salt.
Soaps cleaning agents: castle soap, olive oil based soap.
Perfumes: essential oils provide nontoxic fragrances that can be used to scent shampoo, bath soaks, or even, in the case of peppermint, to flavor toothpaste.
Although it’s easy to make healthful alternatives to many cosmetic and hygiene products, any natural foods store has a fairly wide selection of shampoos, moisturizers, toothpastes, after shaves, soaps, and bath products that do not contain the harmful ingredients in many commercial preparations.
Safe Substitutes for Art and Hobby Materials
There are some nontoxic choices that can be made when buying art or craft supplies, but because some techniques require certain materials, minimizing exposure may be the best you can do.
In painting and print making, ready-mixed water-based paints or links can be used. If you must be exposed to paint dust, use toxic dust respirator approved by the National Institute for Occupational Safety and Health (NIOSH). Ventilate the space thoroughly whenever using any kind of solvents, whether in painting or in lithography, intaglio, or photoetching. Solvents also should be avoided while pregnant.
Enamels are usually lead-based, and can contain other toxic metals such as cadmium and nickel. Use lead-free-enamels whenever possible, and make sure kilns are vented outside.
In pottery as well, outside vented kilns are important, as is a careful choice of materials–most potters know to avoid lead glazes and lead frits, but many don’t know that flint, feldspars, fluorspar, and some compounds containing barium, lithium, manganese, or nickel can also be toxic. Children should avoid the pottery studio, as they are more highly susceptible to the toxics use in pottery than are adults.
Photography presents a number of toxic hazards which are difficult to avoid. Minimize exposure to photo chemical by using gloves, mixing chemicals in a mixing box with holes in the sides for gloved hands, and providing adequate ventilation. The Health and Welfare Office of Canada suggests at least 10 room air changes per hour. Children under 12 should avoid the darkroom.
Safe Substitutes for Pesticides in Home and Garden
Against pests in the home, the best offense is a good defense. The first step is to make the house–especially the kitchen–unattractive to insects by cleaning up food spills immediately, keeping hard-to-reach areas reasonably clean, and removing clutter that can hide pests. Store foods attractive to pests, such as flour, in the refrigerator. water attracts pests, such as flour, in the refrigerator. Water attracts pest, so leaky faucets and pipes should be promptly repaired. Doors and windows should be well screened. Cloths should be regularly cleaned and aired, and properly stored in paper or cardboard boxes sealed against moths.
A Number of nontoxic substances can be used to repel insects, generally, they are highly fragrant or volatize herbs or spices powdered red chill peppermint, bay leaves cloves citrus oil lavender, rosemary, tobacco, peppercorns, and cedar oil can repel various types of insects.
Insects can be trapped and killed without resorting to dangerous chemicals:
Generally a poison nontoxic to humans is mixed with a food that insects find attractive, and spread in the infested area. example are oatmeal (attractive) and plaster-of Paris (poisonous), and cocoa powder and flour (attractive) and borax (poisonous). Old-fashioned flypaper–not a hanging strip of insecticide — is an effective trap. For specific house pests, try these solutions:
For ants: sprinkle powdered red chill pepper, paprika, dried peppermint, or borax where the ants are entering.
For beetles: kill manually when you see them.
For cockroaches: Mix by stirring and sifting 1 ounce TSP, 6 ounces borax, 4 ounces sugar, and 8 ounces flour. Spread on floor of infested area. Repeat after 4 days and again after 2 weeks.
For fleas: Feed pet brewer’s yeast in powder mixed with food or by tablets.
For moths: Air clothes well in the sun; store in airtight containers, and scatter sachets of lavender, cedar chips, or dried tobacco in with clothing.
For rats and mice: Again, prevention may be the best cure. Holes in exterior or interior walls should be closed off and storage spaces kept orderly. Garbage should be kept tightly covered. To catch rodents, the most efficient system is the oldest: a cat. next best are mouse and rat traps.
For termites: Any wooden parts of the house should be at least 18 inches off the ground, as subterranean termites cannot tolerate being exposed to air and light. They have to build easily visible mud tunnels to get at available wood. However, most existing houses have only about an 8 inch clearance between wooden parts and the ground, which makes the wood vulnerable. Metal shields may help discourage termites, but they cannot prevent infestations.
To treat existing termite infestations, there are a few nontoxic alternatives: the “Extermax” system, available in California; and the use of a particular species of nematodes to eat them, a system available from N-Viro Products, Ltc.
For gardens: In hardware stores, look for new brands of safer insecticides that use soap-and water solution to get rid of aphids, or pyrethrum for a number of applications. As more and more people understand the hazards of organic chemicals in the home, market pressure will encourage the introduction of safer products.
Several naturally derived pesticides exist which , in some cases, are less toxic to humans the organophosphates, carbamates, or organochlorines now widely used. Nicotine is the most toxic poisonous both to humans and to other mammals, as well as to birds and fish. It is not available commercially for home gardeners because of its hazards. Rotenone, moderately toxic to humans, kill a wide range of insects; however, it should never be used near a waterway, as it is very toxic to fish. Ryania kills only a few species, including the European corn borer, codling moth, and cranberry fruit worm. Pyrethrum is relatively nontoxic to humans and only slightly toxic to aquatic life, so it may be the best choice for home gardens. Sabadilla controls lice, leafhoppers, squash bugs, striped cucumber beetles, and chinch bugs. It has low toxicity to wildlife, but it may be toxic to bees.
For lawns: herbicides are most often used to kill “unsightly” weeds in gardens and yards, and by lawn care companies to maintain the perfect appearance of turf around homes and on lawns and golf courses. Basically the safe alternative to herbicides is simple: pull weeds by hand. There are no really safe herbicides.
Safe Substitutes for the Patio
A simple and much more effective alternative exists for the charcoal lighter fluid used to start the backyard barbeque. A metal, chimney-pipe cylinder, which holds the charcoal above a burning piece of newspaper and relies on the air flow under the charcoal to quickly bring it to glowing hot, is available at most discount stores. It readies the charcoal for cooking much more quickly without the chemical taste and fire hazard of lighter fluid.
Paint Thinner In Your Cereal??
It’s right in our faces … Just mocking us. Can you believe there is paint thinner in cereal?
Did you know that in the UK, they have their own warning label slapped onto the same Lucky Charms cereal with a description of what this cereal WILL DO to children? It’s because the UK has different labeling laws, and instead of making a whole new box, they put a “sticker” over the US nutritional facts because they are incomplete and don’t state all of the effects of eating said food. Check out the labels, folks, and be thoroughly appalled …

Scientists Officially Link Processed Foods To Autoimmune Disease
The modern diet of processed foods, takeaways and microwave meals could be to blame for a sharp increase in autoimmune diseases such as multiple sclerosis, including alopecia, asthma and eczema.
A team of scientists from Yale University in the U.S and the University of Erlangen-Nuremberg, in Germany, say junk food diets could be partly to blame.
‘This study is the first to indicate that excess refined and processed salt may be one of the environmental factors driving the increased incidence of autoimmune diseases,’ they said.
Is Your Ice Cream Killing You?

Ice cream is a favorite dessert all across the globe, ice cream holds a special place in the hearts of millions. But this is one frozen dessert that you might want to reconsider eating.
Some of your favorite ice cream brands in America contain an ingredient that is banned in many countries around the world like Canada, The European Union, Australia, and New Zealand. Several well-known brands are using milk contaminated with the rBGH growth hormone, engineered by Monsanto. This hormone is marketed towards dairy farmers, to increase the milk production in cows by altering the cow’s hormone levels artificially.
About The Aloha Wellness Company
If you’re reading the postings here, you’re beginning to learn about all the toxic chemicals that are liberally used in retail products you trusted to be “safe” for you, your family, your pets and the Planet. Now, hopefully, you’ll not continue to buy these poisons out of sheer convenience. The Aloha Wellness Company partners with a manufacturer which creates 100% non-toxic products that benefit your body’s health and well-being and are “green” for the planet so our water tables won’t be contaminated … no allergies, no disease, no warning labels that threaten death by exposure or ingestion. We already know our answers and are walking the talk by living Green and toxins-free. The future of the next seven generations is in our collective hands … So, is complacency and convenience going to be your continued way of being in 2015? What’s your Plan B … what are YOU going to do differently to safeguard the wellness of our children TODAY?
























